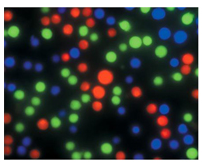

https://www.liankebio.com/article-information_Newsletter-1177.html
作者:Life官网 发布日期:2014-05-13 13:00

本文向各位介绍Life Technologies最受欢迎且使用最简单的细胞器和亚细胞结构荧光染料和荧光蛋白试剂。六、脂滴
脂滴是细胞内中性脂的主要贮存场所,广泛存在于细菌、酵母、植物、昆虫以及动物细胞中。研究表明,脂滴并非细胞内一个简单的能量贮存器,而是一个复杂、活动旺盛、动态变化的多功能细胞器。脂滴能够沿着细胞骨架运动,并与其它细胞器相互作用,可能在脂类代谢与存储、膜转运、蛋白降解,以及信号传导过程中起着重要的作用。另外,多种代谢性疾病,如肥胖、脂肪肝、心血管疾病及糖尿病、中性脂贮存性疾病和Niemann Pick C疾病,往往都伴随着脂质贮存的异常。因此,关于脂滴的生物学研究日益受到人们的重视。
产品列表:
| 货号 |
产品名称 |
Ex/Em |
样本类型 |
可否固定 |
重要特性 |
| HH-H34477 |
LipidTOX™ Deep Red neutral lipid stain |
637/655 |
活细胞/固定细胞 |
是 |
高通量筛选鉴定化学物对哺乳动物细胞系脂代谢的毒副作用,监测成脂分化;对中性脂具有高度特异性;即用型;无需洗涤 |
| HH-H34475 |
LipidTOX™ Green neutral lipid stain |
495/505 |
活细胞/固定细胞 |
是 |
| HH-H34476 |
LipidTOX™ Red neutral lipid stain |
577/609 |
活细胞/固定细胞 |
是 |
七、细胞质
细胞质由细胞质基质、内膜系统、细胞骨架和包涵物组成,在生活状态下为透明胶状物,是生命活动主要场所。
 |
 |
| 图11 Jurkat细胞孵育calcein染料荧光图。Jurkat细胞孵育绿色荧光的calcein AM、CellTrace™ calcein red-orange AM和Calcein Blue, AM进行荧光成像 |
图12 使用CellTracker™ Blue, Green和Red染料对细胞进行多色多日的成像分析。HeLa细胞标记CellTracker® Blue CMAC dye(蓝色)、A549细胞标记CellTracker® Red CMTPX(红色)、BPAE细胞标记CellTracker® Green CMFDA,将三种类型的细胞共培养,3天后进行观察(A)10倍成像;(B)20倍成像。 |
??????
产品列表:??????
| 货号 |
产品名称 |
Ex/Em |
样本类型 |
可否固定 |
重要特性 |
| HH-C3100MP |
Calcein AM |
494/517 |
活细胞 |
否 |
用于检测细胞粘附、趋化性和多药抗药性的最好的探针;较荧光素、羧基二乙酸荧光素和BCECF,可更好地滞留于活细胞中;荧光更亮 |
| HH-C34851 |
CellTrace™ calceinred-orange AM |
576/589 |
活细胞 |
否 |
细胞示踪和细胞活力的指示剂;可与蓝色和绿色荧光搭配 |
| HH-C1429 |
Calcein Blue, AM |
360/449 |
活细胞 |
否 |
|
| HH-C34553 |
CellTrace™ Far Red DDAO-SE |
646/659 |
活细胞 |
否 |
琥珀酰亚胺脂(SE)可与蛋白和生物分子上的伯胺发生强烈的共价结合 |
| HH-C2110 |
CellTracker™ Blue CMAC |
353/466 |
活细胞 |
否 |
在细胞分离时仍有荧光,不会转移至相邻细胞。研究细胞巯基水平、活力和细胞毒性、移植和细胞融合的最佳选择。进入细胞后就滞留在胞内,产生强烈的荧光信号 |
| HH-C7025 |
CellTracker™ Green CMFDA |
492/517 |
活细胞 |
否 |
| HH-C2927 |
CellTracker™ Orange CMTMR |
541/565 |
活细胞 |
否 |
| HH-C34552 |
CellTracker™ Red CMTPX |
577/602 |
活细胞 |
否 |
| HH-Q25041 |
Qtracker® 525 Cell Labeling Kit |
525 |
活细胞 |
是 |
Qtracker® Cell Labeling Kits可用于分裂快速的细胞或胞吞活跃的细胞,包括常见的细胞系如HeLa、CHO、U188和3T3等 |
| HH-Q25031 |
Qtracker® 565 Cell Labeling Kit |
565 |
活细胞 |
是 |
| HH-Q25001 |
Qtracker® 585 Cell Labeling Kit |
585 |
活细胞 |
是 |
| HH-Q25011 |
Qtracker® 605 Cell Labeling Kit |
605 |
活细胞 |
是 |
八、细胞内膜
细胞内膜存在于真核细胞质中各膜结合细胞器中的膜,包括核膜、内质网膜、高尔基体膜、溶酶体膜、线粒体膜、叶绿体膜、过氧化物酶体膜等。
 |
图13 表达GFP偶联tbx6基因的斑马鱼胚胎荧光成像图。斑马鱼胚胎中转染GFP偶联的tbx6基因,在24体节阶段,以CellTrace™ BODIPY® TR methyl ester进行复染成像 |
产品列表:
| 货号 |
产品名称 |
Ex/Em |
样本类型 |
可否固定 |
重要特性 |
| HH-C34556 |
CellTrace™ BODIPY® TR |
598/625 |
活细胞/固定细胞 |
是 |
积累在细胞膜包括浆膜和细胞器膜;是对表达GFP的细胞和组织进行复染的极佳染料 |
| HH-I34407 |
Image-IT® LIVE Intracellular Membrane and Nuclear Labeling Kit |
350/461 (Hoechst 33342) 598/625 (BODIPY® dye) |
活细胞/固定细胞 |
是 |
包含CellTrace™ BODIPY® TR methyl ester和Hoechst 33343,可选择性地对转染GFP活细胞进行胞内膜和细胞核染色 |
|